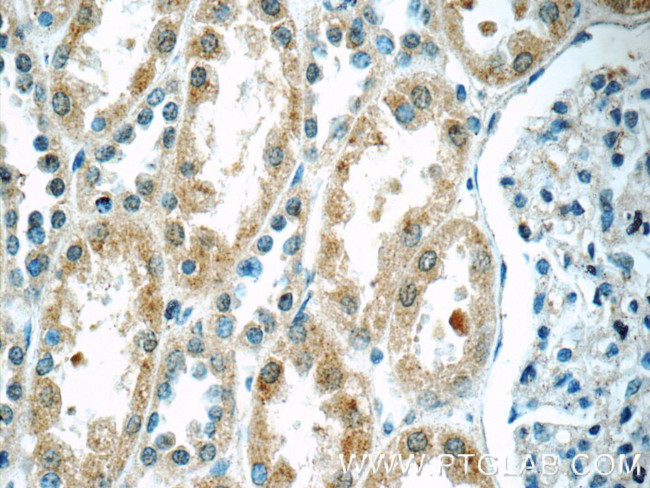
TWSG1 Antibody in Immunohistochemistry (Paraffin) (IHC (P))

Search
Proteintech
TWSG1 Polyclonal Antibody
{{$productOrderCtrl.translations['antibody.pdp.commerceCard.promotion.promotions']}}
{{$productOrderCtrl.translations['antibody.pdp.commerceCard.promotion.viewpromo']}}
{{$productOrderCtrl.translations['antibody.pdp.commerceCard.promotion.promocode']}}: {{promo.promoCode}} {{promo.promoTitle}} {{promo.promoDescription}}. {{$productOrderCtrl.translations['antibody.pdp.commerceCard.promotion.learnmore']}}
产品信息
12327-1-AP
种属反应
宿主/亚型
分类
类型
抗原
偶联物
形式
浓度
规格
纯化类型
保存液
内含物
保存条件
运输条件
产品详细信息
The MW of this protein is 45 kDa, and this antibody specifically recognizes the 45 kDa protein.
Immunogen sequence: LMFLTWLPE SLSCNKALCA SDVSKCLIQE LCQCRPGEGN CSCCKECMLC LGALWDECCD CVGMCNPRNY SDTPPTSKST VEELHEPIPS LFRALTEGDT QLNWNIVSFP VAEELSHHEN LVSFLETVNQ PHHQNVSVPS NNVHAPYSSD KEHMCTVVYF DDCMSIHQCK ISCESMGASK YRWFHNACCE CIGPECIDYG SKTVKCMNCM F (14-223 aa encoded by BC020490)
靶标信息
TWSG1 may be involved in dorsoventral axis formation. Seems to antagonize BMP signaling by forming ternary complexes with CHRD and BMPs, thereby preventing BMPs from binding to their receptors. In addition to the anti-BMP function, also has pro-BMP activity, partly mediated by cleavage and degradation of CHRD, which releases BMPs from ternary complexes. May be an important modulator of BMP-regulated cartilage development and chondrocyte differentiation. May play a role in thymocyte development.
仅用于科研。不用于诊断过程。未经明确授权不得转售。
篇参考文献 (0)
生物信息学
蛋白别名: twisted gastrulation homolog 1; Twisted gastrulation protein homolog 1; unnamed protein product
基因别名: 1810013J15Rik; 9030422N06Rik; AW552143; D17Ertd403e; PSEC0250; TSG; Twg; TWSG1
UniProt ID: (Human) Q9GZX9, (Mouse) Q9EP52
Entrez Gene ID: (Human) 57045, (Mouse) 65960, (Rat) 363294